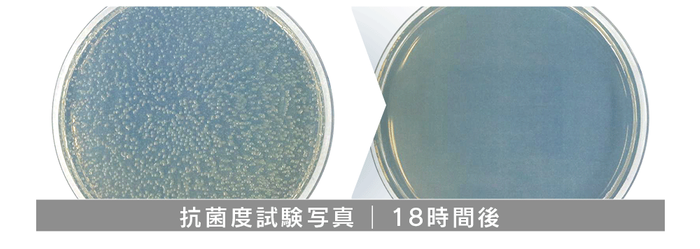
抗菌度試験

株式会社AJAX(本社:山形県山形市、代表取締役:李 容仁)は、アレルギー対策に特化したクローゼット用多機能ハンガー型空気清浄機「CLOSET MATE」を、2024年7月1日より発売いたします。
新型コロナウイルスの感染拡大以降、人々の衛生意識は大きく変化しました。外出時の手洗い、消毒はもちろんのこと、家庭内での衛生管理にも注目が集まっています。特に、毎日身につける衣類の清潔さは、多くの人々にとって重要な関心事となっています。
また、近年、日本国内でのアレルギー疾患患者数は増加の一途を辿っており、特に花粉症やハウスダストアレルギーに悩む人々が急増しています。厚生労働省の調査によると、国民の約2人に1人が何らかのアレルギー症状を抱えているとされ、その対策は喫緊の課題となっています。
このような社会のニーズに応えるべく「CLOSET MATE」は、日常生活の中で最も身近な空間であるクローゼットに着目し、単なる空気清浄機ではなく、衣類を守る専用デバイスとして開発しました。
「CLOSET MATE」は、クローゼット内の空気を24時間365日、静かに清浄し続け常にクリーンな状態に保ちます。
特殊な3層フィルターシステムにより、ウイルスや細菌を99.5%除去するだけでなく、消臭・抗菌・除湿・芳香の機能も備えた多機能デバイスです。


本製品の最大の特徴は、H13クラス*(ISO35同等)のHEPAフィルターを搭載していることです。このフィルターは、花粉やハウスダスト、PM2.5などの微細な粒子を99.5%除去する高い性能を持っています。さらに、抗菌フィルターを組み合わせることで、アレルギーの原因となる細菌の繁殖も効果的に抑制します。
ウイルス対策はもちろん、花粉やPM2.5対策、さらには生活臭の除去まで、衣類に関するあらゆる悩みを解決する製品です。

さらに、「CLOSET MATE」は単なる空気清浄機にとどまらず、除湿機能も備えています。付属の抗菌除湿剤バッグにより、ジメジメした梅雨の時期や高温多湿の夏場でも、クローゼット内を快適な湿度に保ちます。これにより、衣類のカビや匂いの発生を予防し、大切な洋服を長く美しく保つことができます。
クローゼットという小さな空間から始めることで、家全体の空気質改善にもつながると確信しています。

【CLOSET MATEの主な特長】
スマートエアサーキュレーション方式による静音設計
- 20~25dBの超静音設計で、就寝中も気にならない動作音
- 1~2時間ごとの自動運転で効率的に空気を清浄

高性能3層フィルターシステム
- プレフィルター:生活臭や動物の毛、粗いホコリを除去
- H13クラスHEPAフィルター:0.3μmの微粒子を99.31%以上ろ過
- 抗菌フィルター:各種細菌の成長を99%以上抑制
フランス直輸入の6種類のアロマオプション
- 高級ホテルでも使用されるラグジュアリーな香り
- Sensual oud wood、Chic and lime、My Magnolia、In the sea、For Rest with me、Lovely Sandalwoodの6種類
- 約3ヶ月持続する長期使用可能なアロマフィルター

USB Type-C充電で約1ヶ月連続使用可能
- 約3時間の充電で約1ヶ月使用可能な大容量バッテリー
- 一般的なスマートフォン用充電器で簡単に充電可能

コンパクトで使いやすいデザイン
- クローゼットのポールにかけるだけの簡単設置
- 253 x 46 x 99 mmのコンパクトサイズで場所を取らない
- 約200gの軽量設計

交換式抗菌除湿剤バッグ
- 1~3ヶ月使用可能な高性能除湿剤(使用環境によります)
- 湿気を吸収しながら菌の繁殖も防止

さらに、「CLOSET MATE」は以下のような使用シーンでその真価を発揮します。
・外出後の衣類ケア:外出時に付着した可能性のあるウイルスや細菌を除去
・季節の変わり目の衣替え:長期保管していた衣類の消臭・除菌
・梅雨時期の湿気対策:クロージェットの湿気取りと衣類のカビ予防と不快な臭いの軽減
・ペットのいる家庭:動物の毛や臭いの除去

【製品仕様】
サイズ:253 x 46 x 99 mm
重量:約200 g
材質:ABS、SUS
充電:USB Type-C
電池容量:3000 mAh Li-ion充電池
充電時間:約3~4時間
連続使用時間:2分作動後1時間停止繰り返し、満充電後1ヶ月持続
フィルター:H13クラスHEPAフィルター
価格:5,800円(税別)
発売日:2024年7月1日
販売チャネル:当社公式オンラインストア、インターネット通販サイト
会社概要
企業名: 株式会社AJAX
代表者: 李 容仁
所在地: 山形県山形市双月町2-6-3
設立: 2008年6月13日
事業内容: 輸出入・卸・酒類輸出入・販売など